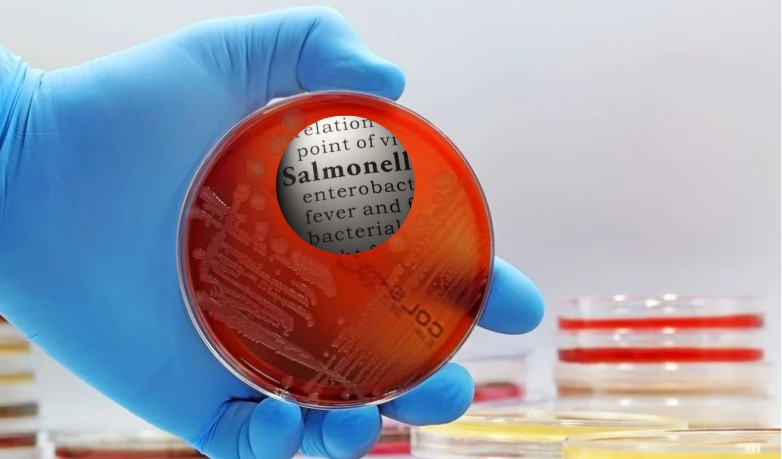
Bharat Biotech Paratyphi Vaccine

November 1, 2025: Bharat Biotech’s oral paratyphoid vaccine candidate has been featured in the New England Journal of Medicine, reporting the first-ever human protection against Salmonella Paratyphi A—a pathogen for which no licensed vaccine currently exists. The study marks a pivotal moment in enteric fever research, offering new hope for integrated typhoid–paratyphoid prevention strategies.
The vaccine, known as CVD 1902, demonstrated 73% protection in a controlled human infection model. This is the first human evidence that a modern paratyphoid vaccine can work, potentially opening the door to future bivalent formulations that target both typhoid and paratyphoid strains.
NEJM Study Marks Milestone in Bharat Biotech’s Paratyphoid Prevention Vaccine

As part of the global development effort, Bharat Biotech’s teams in Hyderabad supported process development and GMP scale-up of the live-attenuated oral candidate. The company’s contribution builds on its established expertise in typhoid conjugate vaccines and reflects its commitment to equitable access in low-resource settings according to Dr. Raches Ella, Chief Development Officer, Bharat Biotech.
The study was led by the Oxford Vaccine Group and the University of Maryland’s Center for Vaccine Development. Researchers emphasized that while the controlled model offers strong early data, further trials in endemic regions will be essential to validate real-world effectiveness.
This collaboration between academic research and manufacturing expertise illustrates a model for translating scientific breakthroughs into scalable public health solutions.
In a double-blind, randomized, placebo-controlled trial, the study evaluated an orally administered live, attenuated S. Paratyphi A vaccine (CVD 1902) using a controlled human infection model. Healthy U.K. adults were assigned in a 1:1 ratio to receive two doses of CVD 1902 or placebo 14 days apart. Twenty-eight days after the second dose, participants were challenged orally with S. Paratyphi A. The primary end point was a diagnosis of S. Paratyphi A infection within 14 days after challenge. Secondary end points included safety and immunogenicity.
Salmonella enterica serovar Paratyphi A (also known as S. Paratyphi A) is responsible for more than 2 million cases of enteric fever annually. There are no licensed vaccines against S. Paratyphi A.